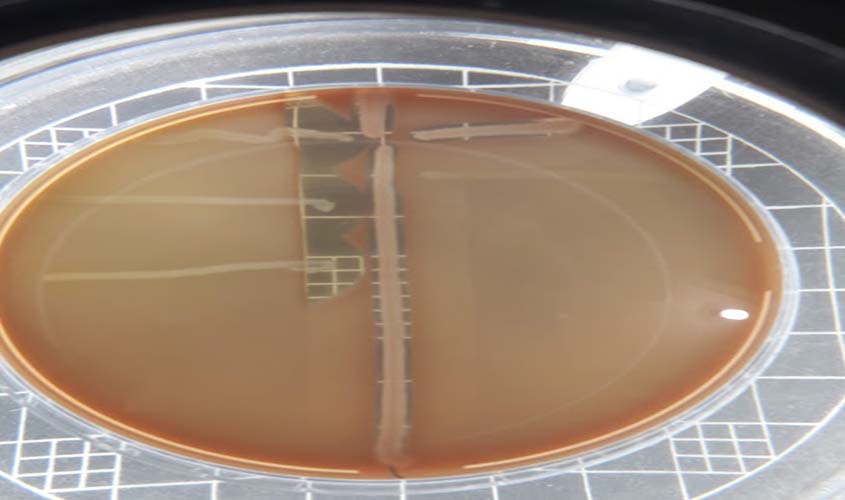

Laboratório da Fiocruz Rondônia realiza exame de rastreio bacteriano em gestantes
O exame possibilita a identificação da bactéria Streptococcus agalactiae, normalmente encontrada no aparelho digestivo e canal vaginal de mulheres. Em casos de gravidez, pode ocorrer a transmissão da bactéria para o bebê, trazendo riscos à saúde do recém-nascido
Teste CAMP para identificação de EGB
O laboratório de Microbiologia da Fiocruz Rondônia tem realizado exame para rastreio da bactéria Streptococcus agalactiae, também conhecida como Estreptococos do Grupo B (EGB), em gestantes de Porto Velho-RO. Esta bactéria é normalmente encontrada no aparelho digestivo de seres humanos e diferentes animais, sendo que em mulheres é muito comum no canal vaginal, sem que isso cause alguma doença.
No entanto, em mulheres grávidas, colonizadas pela bactéria, pode ocorrer a transmissão deste micro-organismo para o recém-nascido, ocasionando riscos à saúde do bebê, “que poderá desenvolver doenças graves como pneumonia, meningite e sepse”, explica o pesquisador Roger Lafontaine, autor do estudo.
O pesquisador também esclarece que, atualmente, não temos na rede pública de saúde um exame específico disponibilizado pelo Sistema Único de Saúde (SUS), para detectar a presença desta bactéria em mulheres grávidas, sendo possível o seu diagnóstico somente na rede particular.
De acordo com o pesquisador, “na prática, o estudo evidencia a necessidade de ampliar o atendimento a todas as gestantes, uma vez que confirmada a presença desta bactéria na paciente, poderão ser tomadas medidas preventivas em relação à saúde do bebê”. Atualmente, as coletas para a pesquisa são realizadas em Unidades Básicas de Saúde, em colaboração com a Secretaria Municipal de Saúde (Semusa), e no Centro Comunitário de uma faculdade particular de Porto Velho.
Após a análise, os resultados são entregues à unidade na qual foi realizada a coleta. Nas gestantes colonizadas pela bactéria, a prevenção se dá por meio de antibióticos ministrados no momento do parto, sendo essa uma decisão da equipe médica. Segundo Roger, o exame consiste em coletar uma amostra do canal vaginal e retal da gestante, entre 35 e 37 semanas, por meio de um swab, cotonete específico para a coleta de material biológico.

Equipe da Friocruz Rondônia que desenvolve a pesquisa
Em casos suspeitos de infecção, as pacientes são orientadas a observar no recém-nascido sintomas como febre ou hipotermia, irritação, dificuldades na amamentação e falta de ar, durante a primeira semana de vida. Essas orientações são válidas, principalmente, para as gestantes que tiveram a presença da bactéria Estreptococos do Grupo B confirmada no organismo.
DADOS DA PESQUISA
Mesmo parciais, os dados da pesquisa são expressivos. Até o momento, foram coletadas 426 amostras de mulheres grávidas, sendo que 98 delas (23%) estavam colonizadas com a bactéria. As análises também indicaram que os micro-organismos isolados são sensíveis aos antibióticos utilizados de forma preventiva (profilaxia), que são ampicilina e penicilina, principalmente, com taxas de resistência de 2 e 6%, respectivamente.
O estudo denominado “Prevalência da colonização por Estreptococos do grupo B em gestantes do município de Porto Velho-RO” tem o financiamento da Fundação de Amparo ao Desenvolvimento das Ações Científicas e Tecnológicas e à Pesquisa de Rondônia (Fapero) e do Programa Pesquisa para o SUS (PPSUS). Sob a orientação da doutora Najla Benevides Matos, pesquisadora em Saúde Pública da Fiocruz RO e chefe do Laboratório de Microbiologia, a pesquisa apresenta-se como alternativa para a prevenção da infecção pela bactéria Estreptococos do Grupo B em recém-nascidos. O projeto conta ainda com a participação da enfermeira Mariana Delfino Rodrigues, doutoranda em Ciências Biomédicas. Para Najla Matos, entre os resultados obtidos com o estudo, “a partir do rastreamento da bactéria, em tempo oportuno, pode-se ter um impacto na redução de problemas de saúde pública como a sepse neonatal, por meio da adoção de medidas preventivas”.
O estudo continua com as coletas, dando grande colaboração à saúde das gestantes atendidas nas unidades básicas de saúde em Porto Velho. Roger salienta que as mulheres que fazem pré-natal na rede privada e/ou comunitária e que desejarem fazer o exame, este será realizado gratuitamente, sendo necessário apenas o agendamento da coleta pelo telefone (69) 9 9223-4620 (Roger) ou (69) 3216-5442 (Cepem/Microbiologia).
Aeroportos de Rondônia recebem aval de Ministério da Infraestrutura para andamento da execução das obras
Celeridade nos projetos de aeroportos de Rondônia são demandados pelo Departamento de Estradas de Rodagem, Infraestrutura e Serviços Públicos (DER), pelo diretor-geral coronel Erasmo Meireles, em Brasília
Três escolas municipais em reforma retomam as aulas até dia 9 de março
A Semed informa que os alunos não vão ficar prejudicados quanto ao calendário porque será feita uma reorganização e serão cumpridos os 200 dias letivos
IBGE anuncia 208 mil vagas em concurso para o Censo 2020
Salários vão até R$2.100 para as vagas de recenseador e agente censitário.




Comentários
Seja o primeiro a comentar
Envie Comentários utilizando sua conta do Facebook